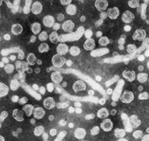

|
Gibelari erasotzen dion birus batek sorturiko gaixotasun infekzioso biriko bat da. Gibelari erasotzen dion birus batek sorturiko gaixotasun infekzioso biriko bat da.
Birusak, B hepatitisaren birusa (BHB) deritzonak, eragin dezake biziarteko infekzio bat, denborarekin zirrosi hepatikoa, gibeleko minbizia, gibelaren hondamena eta heriotza ekar ditzakeena.
B hepatitisa kutsatzeko bi era daude. Bat era horizontala izenaz ezagutzen dena da, gehienetan odol infektatuaren ukipenaz gertatzen dena. Beste kutsapen era bertikala izenaz ezagutzen dena da, alegia, amagandik umeagana igortzen dena, jaiotzeko unean.
Pertsona batek infekzioa harrapatzeko arriskua handiagoa dauka, baldin:
- BHB daukan norbaitekin sexu harremanak baditu.
- Sexu harremanak bikotekide askorekin baditu.
- Drogak injektatzen baditu.
- BHBagatiko infekzio kronikoa daukan norbaitekin bizi bada.
- Bere lanean giza odolarekin ukipenean jarduten badu.
- Defizit psikiko garrantzitsuren bat badauka edo paziente hauek dauden erakunderen batean lan egiten badu.
- Hemofilia badauka.
- B hepatitisa zabaldua dagoen lurralderen batera bidaiatzen badu.
Infekzio honi eta bere ondorioei aurre egiteko neurri eraginkorrena txertaketa da. 80ko hamarkadaren erditik hona, Eusko Jaurlaritzako Osasun Sailak txertaketa selektibo bat egiten du arrisku handienekotzat jotzen diren taldeetan. Gainera, B hepatitisaren aurkako txertoa ematen zaie haurrei bi hilabete dituztenetik aurrera, eta 13 urteko gazteei. Honela, infekzio honek eragindako heriotza kasuak eta eramaile kronikoen kopurua murriztu nahi dira, etorkizunean gaixotasun hau errotik erauzteko oinarriak finkatzeko.
|